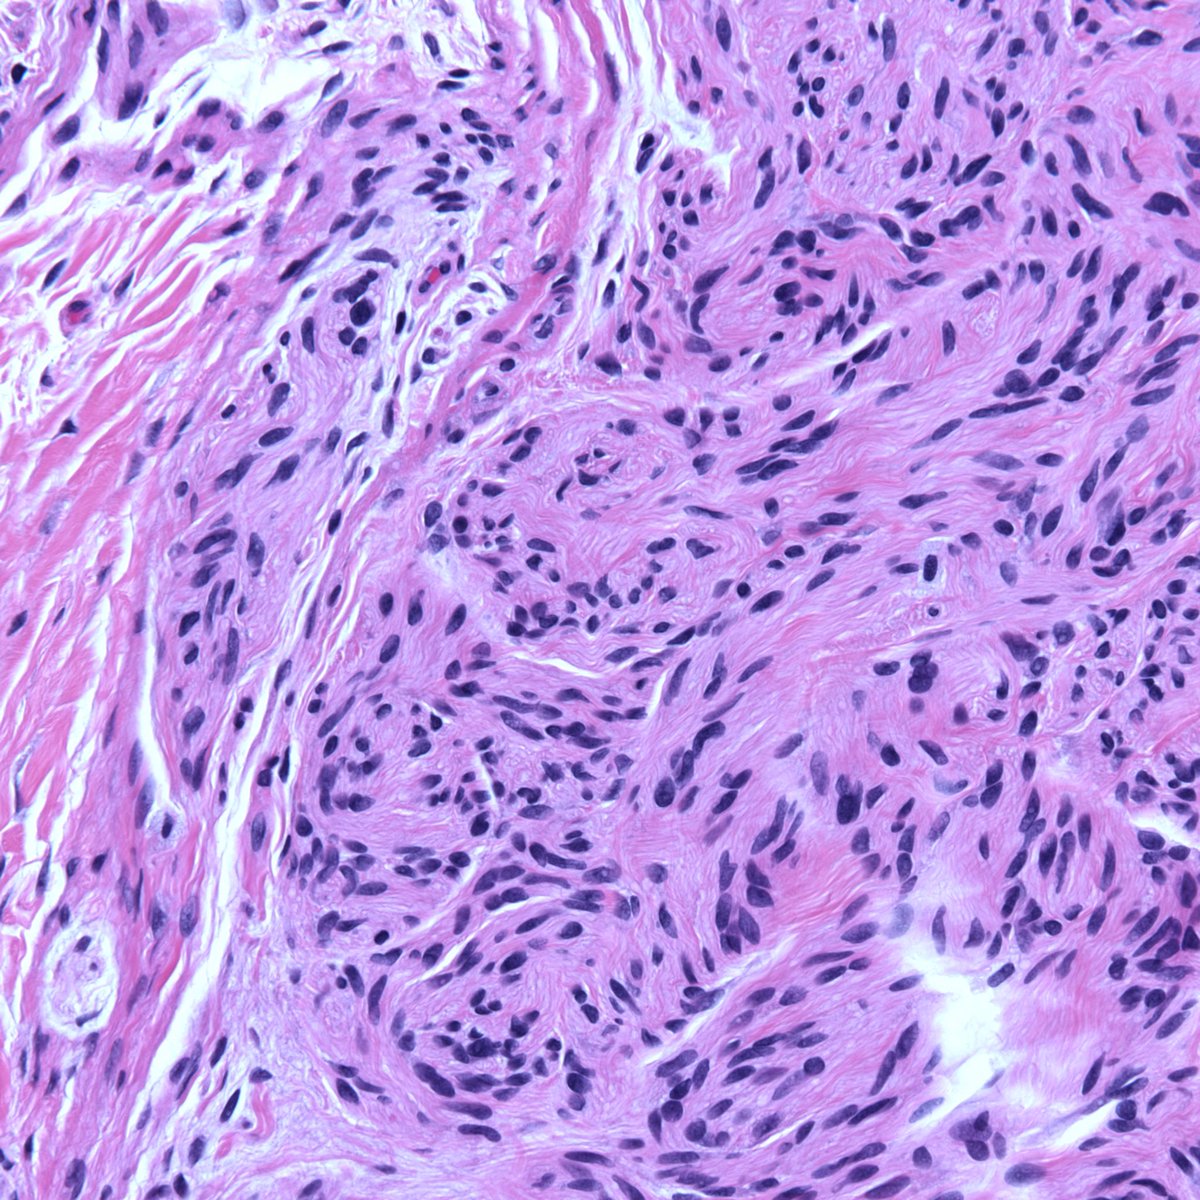
Adult, face lesion—some clues to site here. #dermpath #pathology #dermatology #dermtwitter

AKINA
@drakinap
Oncopathology fellow
ID: 144851672
17-05-2010 13:34:10
51 Tweet
129 Followers
355 Following



Tumor emboli within lymph node capsule only . Is it involvement or not? Opinions pls. Vidya Monappa Tristan Rutland MBBS FRCPA IFCAP Dr. Luca Jayanthi Kamashi Henry YANG AKINA













Just Out! Check our review on adenoid cystic carcinoma and perspectives on future treatment options. #headandnecktumors #raretumors #ACC Felippe Lazar RenataFerrarotto @MDAndersonNews



68 yr old male, Left nephrectomy. Any DDs on gross ? International Society of Urological Pathology krithika elangovan @Jazzopath1 libin babu GU Pathology Society (GUPS) @Ranju35760436 Karnataka Chapter-IAPM (KCIAPM)